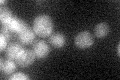
YOR363C
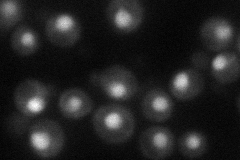
YOR363C
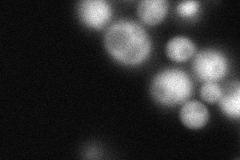
YOR363C
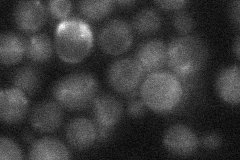
YOR363C

View description
Autoregulatory oleate-specific transcriptional activator of peroxisome proliferation, contains Zn(2)-Cys(6) cluster domain, forms heterodimer with Oaf1p, binds oleate response elements (OREs), activates beta-oxidation genes
Localization:
Intensity:
Fold change:
Significance:
-
C’ GFP library in SD
nucleus17.2 -
N' NOP1pr-GFP in SD
nucleus43.994 -
N' TEF2pr-mCherry in SD
nucleus33.7668 -
N' NATIVEpr-GFP in SD
ambiguous22.5075 -
N' TEF2pr-VC and Cyto-VN in SD

punctate,nucleus29.2236 -
C’ GFP library in SD+DTT

nucleus15.020.87No -
C’ GFP library in SD+H2O2

nucleus20.711.2No -
C’ GFP library in Starvation Media

nucleus18.341.06No -
C’ GFP library on the background of Pup2-DaMP

N/A -
C’ GFP library on the background of CCT mutant

N/A0N/AYes
